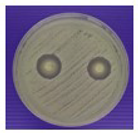
Polymers 15 03572 i003
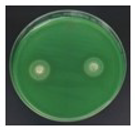
Polymers 15 03572 i004
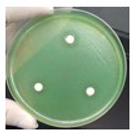
Polymers 15 03572 i006

Surface-Modified Carboxylated Cellulose Nanofiber Hydrogels for Prolonged Release of Polyhexamethylene Biguanide Hydrochloride (PHMB) for Antimicrobial Applications
Abstract
:1. Introduction
2. Materials and Methods
2.1. Materials
2.2. Preparation of Carboxylated Cellulose Nanofibers
2.3. Yield Measurement
2.4. Morphological Characterizations of u-CNFs and c-CNFs
2.5. Fourier Transform Infrared Spectroscopy (FTIR)
2.6. Determination of the Degree of Oxidation and the Carboxylic acid Content of Carboxylated Cellulose Nanofibers
2.7. X-ray Diffraction (XRD) Analysis of u-CNFs and c-CNFs
2.8. Preparation of Carboxylated Cellulose Nanofiber Hydrogels
2.9. c-CNF Hydrogel Characterizations
2.9.1. Morphological Characterizations
2.9.2. Fourier Transform Infrared Spectroscopy
2.9.3. Mechanical Strength Test
2.9.4. Gel Content
2.9.5. Swelling Ratio
2.10. PHMB Loading Content
2.11. In Vitro Drug Release Profile
2.12. Antimicrobial Test
2.13. Statistical Analysis
3. Results and Discussion
3.1. Preparation and Morphological Characteristics of c-CNFs
3.2. Fourier Transform Infrared Spectroscopy (FTIR)
3.3. Degree of Oxidation, Carboxylic Acid Content, and X-ray Diffraction (XRD) Analysis of u-CNFs and c-CNFs
3.4. Preparation and Morphological Characteristics of c-CNF Hydrogels
3.5. Fourier Transform Infrared Spectroscopy (FTIR) of c-CNF Hydrogels Loading PHMB
3.6. Puncture Strength, Gel Content, Maximum Swelling Degree, and Drug Content of c-CNF Hydrogel Loaded with PHMB
3.7. In Vitro Drug Release Profile of c-CNFs Hydrogel Loading PHMB
3.8. Antibacterial Activity of c-CNF Hydrogel Loaded with PHMB
4. Conclusions
Supplementary Materials
Author Contributions
Funding
Institutional Review Board Statement
Informed Consent Statement
Data Availability Statement
Acknowledgments
Conflicts of Interest
References
- Moon, R.J.; Martini, A.; Nairn, J.; Simonsen, J.; Youngblood, J. Cellulose nanomaterials review: Structure, properties and nanocomposites. Chem. Soc. Rev. 2011, 40, 3941–3944. [Google Scholar] [CrossRef] [PubMed]
- Sharma, A.; Thakur, M.; Bhattacharya, M.; Mandal, T.; Goswami, S. Commercial Application of Cellulose Nano-composites—A review. Biotechnol. Rep. 2019, 21, e00316. [Google Scholar] [CrossRef] [PubMed]
- Eyley, S.; Thielemans, W. Surface modification of cellulose nanocrystals. Nanoscale 2014, 6, 7764–7779. [Google Scholar] [CrossRef] [PubMed]
- Kargarzadeh, H.; Mariano, M.; Gopakumar, D.; Ahmad, I.; Thomas, S.; Dufresne, A.; Huang, J.; Lin, N. Advances in cellulose nanomaterials. Cellulose 2018, 25, 2151–2189. [Google Scholar] [CrossRef]
- Tejado, A.; Alam, M.N.; Antal, M.; Yang, H.; van de Ven, T.G.M. Energy requirements for the disintegration of cellulose fibers into cellulose nanofibers. Cellulose 2012, 19, 831–842. [Google Scholar] [CrossRef]
- Li, X.; Ye, D.; Xiang, Z.; Wang, H.; Wang, H.; Lu, Y.; Yao, R. High-performance nanomesh-structured cellulose as a versatile pharmaceutical excipient. Ind Crops Prod. 2023, 197, 116580. [Google Scholar] [CrossRef]
- Fernandes, E.M.; Pires, R.A.; Mano, J.F.; Reis, R.L. Bionanocomposites from lignocellulosic resources: Properties, applications and future trends for their use in the biomedical field. Prog. Polym. Sci. 2013, 38, 1415–1441. [Google Scholar] [CrossRef]
- Lin, N.; Dufresne, A. Nanocellulose in biomedicine: Current status and future prospect. Eur. Polym. J. 2014, 59, 302–325. [Google Scholar] [CrossRef]
- Shi, Z.; Gao, X.; Ullah, M.W.; Li, S.; Wang, Q.; Yang, G. Electroconductive natural polymer-based hydrogels. Biomaterials 2016, 111, 40–54. [Google Scholar] [CrossRef]
- Ul-Islam, M.; Ullah, M.W.; Khan, S.; Kamal, T.; Ul-Islam, S.; Shah, N.; Park, J.K. Recent advancement in cellulose based nanocomposite for addressing environmental challenges. Recent Pat. Nanotechnol. 2016, 10, 169–180. [Google Scholar] [CrossRef]
- O-chongpian, P.; Na Takuathung, M.; Chittasupho, C.; Ruksiriwanich, W.; Chaiwarit, T.; Baipaywad, P.; Jantrawut, P. Composite nanocellulose fibers-based hydrogels loading clindamycin HCl with Ca2+ and citric acid as crosslinking agents for pharmaceutical applications. Polymers 2021, 13, 4423. [Google Scholar] [CrossRef] [PubMed]
- Liu, Y.; Sui, Y.; Liu, C.; Liu, C.; Wu, M.; Li, B.; Li, Y. A physically crosslinked polydopamine/nanocellulose hydrogel as potential versatile vehicles for drug delivery and wound healing. Carbohydr. Polym. 2018, 188, 27–36. [Google Scholar] [CrossRef] [PubMed]
- Liu, R.; Dai, L.; Si, C.; Zeng, Z. Antibacterial and hemostatic hydrogel via nanocomposite from cellulose nanofibers. Carbohydr. Polym. 2018, 195, 63–70. [Google Scholar] [CrossRef] [PubMed]
- Yuan, Z.; Meng, D.; Wu, Y.; Tang, G.; Liang, P.; Xin, J.H.; Ye, D. Raman imaging-assisted customizable assembly of MOFs on cellulose aerogel. Nano Res. 2022, 15, 2599–2607. [Google Scholar] [CrossRef]
- Liang, A.; Zhang, M.; Luo, H.; Niu, L.; Feng, Y.; Li, M. Porous poly(hexamethylene biguanide) hydrochloride loaded silk fibroin sponges with antibacterial function. Materials 2020, 13, 285. [Google Scholar] [CrossRef]
- Sowlati-Hashjin, S.; Carbone, P.; Karttunen, M. Insights into the Polyhexamethylene Biguanide (PHMB) Mechanism of Action on Bacterial Membrane and DNA: A Molecular Dynamics Study. J. Phys. Chem. B 2020, 124, 4487–4497. [Google Scholar] [CrossRef]
- Chindera, K.; Mahato, M.; Kumar Sharma, A.; Horsley, H.; Kloc-Muniak, K.; Kamaruzzaman, N.F.; Kumar, S.; McFarlane, A.; Syach, J.; Bentin, T.; et al. The antimicrobial polymer PHMB enters cells and selectively condenses bacterial chromosomes. Sci. Rep. 2016, 6, 23121. [Google Scholar] [CrossRef]
- Rembe, J.D.; Fromm-Dornieden, C.; Schäfer, N.; Böhm, J.K.; Stuermer, E.K. Comparing two polymeric biguanides: Chemical distinction, antiseptic efficacy and cytotoxicity of polyaminopropyl biguanide and polyhexamethylene biguanide. J. Med. Microbiol. 2016, 65, 867–876. [Google Scholar] [CrossRef]
- Guiomar, A.J.; Urbano, A.M. Polyhexanide-Releasing Membranes for Antimicrobial Wound Dressings: A Critical Review. Membranes 2022, 12, 1281. [Google Scholar] [CrossRef]
- Eberlein, T.; Haemmerle, G.; Signer, M.; Gruber-Moesenbacher, U.; Traber, J.; Mittlboeck, M.; Abel, M.; Strohal, R. Comparison of PHMB-containing dressing and silver dressings in patients with critically colonised or locally infected wounds. J. Wound Care 2012, 21, 12–20. [Google Scholar] [CrossRef]
- Jin, J.; Chen, Z.L.; Xiang, Y.; Tang, T.; Zhou, H.; Hong, X.D.; Fan, H.; Zhang, X.D.; Luo, F.P.; Ma, B.; et al. Development of a PHMB hydrogel-modified wound scaffold dressing with antibacterial activity. Wound Repair Regen. 2020, 28, 480–492. [Google Scholar] [CrossRef] [PubMed]
- Napavichayanun, S.; Amornsudthiwat, P.; Pienpinijtham, P.; Aramwit, P. Interaction and effectiveness of antimicrobials along with healing-promoting agents in a novel biocellulose wound dressing. Mater. Sci. Eng. C 2015, 55, 95–104. [Google Scholar] [CrossRef]
- Basu, A.; Lindh, J.; Ålander, E.; Strømme, M.; Ferraz, N. On the use of ion-crosslinked nanocellulose hydrogels for wound healing solutions: Physicochemical properties and application-oriented biocompatibility studies. Carbohydr. Polym. 2017, 174, 299–308. [Google Scholar] [CrossRef]
- Lin, N.; Bruzzese, C.; Dufresne, A. TEMPO-Oxidized Nanocellulose Participating as Crosslinking Aid for Alginate-Based Sponges. ACS Appl. Mater. Interfaces 2012, 4, 4948–4959. [Google Scholar] [CrossRef] [PubMed]
- Li, M.; Yan, P.; Liu, J.; Pei, Y.; Zheng, X.; Tang, K.; Wang, F. One-step hydrolysis for the preparation of carboxylated cellulose nanofibrils with highly stable dispersibility from pomelo peel. Cellulose 2022, 29, 1609–1621. [Google Scholar] [CrossRef]
- Hassan, S.H.; Velayutham, T.S.; Chen, Y.W.; Lee, H.V. TEMPO-oxidized nanocellulose films derived from coconut residues: Physicochemical, mechanical and electrical properties. Int. J. Biol. Macromol. 2016, 180, 392–402. [Google Scholar] [CrossRef]
- Chanabodeechalermrung, B.; Chaiwarit, T.; Sommano, S.R.; Rachtanapun, P.; Kantrong, N.; Chittasupho, C.; Jantrawut, P. Dual Crosslinked Ion-Based Bacterial Cellulose Composite Hydrogel Containing Polyhexamethylene Biguanide. Membranes 2022, 12, 825. [Google Scholar] [CrossRef]
- Thomas, B.; Raj, M.C.; Joy, J.; Moores, A.; Drisko, G.L.; Sanchez, C. Nanocellulose, a versatile green platform: From biosources to materials and their applications. Chem. Rev. 2018, 118, 11575–11625. [Google Scholar] [CrossRef]
- Wang, J.; Liu, X.; Jin, T.; He, H.; Liu, L. Preparation of nanocellulose and its potential in reinforced composites: A review. J. Biomater. Sci. Polym. Ed. 2019, 30, 919–946. [Google Scholar] [CrossRef]
- Jiang, F.; Hsieh, Y.L. Self-assembling of TEMPO oxidized cellulose nanofibrils as affected by protonation of surface carboxyls and drying methods. ACS Sustain. Chem. Eng. 2016, 4, 1041–1049. [Google Scholar] [CrossRef]
- Hop, T.T.T.; Mai, D.T.; Cong, T.D.; Nhi, T.T.Y.; Loi, V.D.; Huong, N.T.M.; Tung, N.T. A comprehensive study on preparation of nanocellulose from bleached wood pulps by TEMPO-mediated oxidation (FTIR). Results Chem. 2022, 4, 100540. [Google Scholar]
- Gond, R.K.; Gupta, M.K.; Jawaid, M. Extraction of nanocellulose from sugarcane bagasse and its characterization for potential applications. Polym. Compos. 2021, 42, 5400–5412. [Google Scholar] [CrossRef]
- Xu, H.; Sanchez-Salvador, J.L.; Balea, A.; Blanco, A.; Negro, C. Optimization of reagent consumption in TEMPO-mediated oxidation of Eucalyptus cellulose to obtain cellulose nanofibers. Cellulose 2022, 29, 6611–6627. [Google Scholar] [CrossRef]
- Jiao, L.; Bian, H.; Gao, Y.; Lin, X.; Zhu, W.; Dai, H. Highly dispersible cellulose nanofibrils produced via mechanical pretreatment and TEMPO-mediated oxidation. Fibers Polym. 2018, 19, 2237–2244. [Google Scholar] [CrossRef]
- Barbash, V.A.; Yashchenko, O.V.; Gondovska, A.S.; Deykun, I.M. Preparation and characterization of nanocellulose obtained by TEMPO-mediated oxidation of organosolv pulp from reed stalks. Appl. Nanosci. 2021, 4, 835–848. [Google Scholar] [CrossRef]
- Kadry, G.; El-Hakim, A.E.F. Effect of nanocellulose on the biodegradation, morphology and mechanical properties of polyvinylchloride/nanocellulose nanocomposites. Res. J. Pharm. Biol. Chem. Sci. 2015, 6, 659–666. [Google Scholar]
- Habibi, Y.; Chanzy, H.; Vignon, M.R. TEMPO-mediated surface oxidation of cellulose whiskers. Cellulose 2006, 13, 679–687. [Google Scholar] [CrossRef]
- Isogai, A. Development of completely dispersed cellulose nanofibers. Proc. Jpn. Acad. A Math. Sci. 2018, 94, 161–179. [Google Scholar] [CrossRef]
- Madivoli, E.S.; Kareru, P.G.; Gachanja, A.N.; Mugo, S.M.; Sujee, D.M.; Fromm, K.M. Isolation of cellulose nanofibers from Oryza sativa residues via TEMPO mediated oxidation. J. Nat. Fibers 2022, 19, 1310–1322. [Google Scholar] [CrossRef]
- Xie, J.; Hse, C.-Y.; De Hoop, C.F.; Hu, T.; Qi, J.; Shupe, T.F. Isolation and characterization of cellulose nanofibers from bamboo using microwave liquefaction combined with chemical treatment and ultrasonication. Carbohydr. Polym. 2016, 151, 725–734. [Google Scholar] [CrossRef]
- Blackburn, R.S.; Harvey, A.; Kettle, L.L.; Payne, J.D.; Russell, S.J. Sorption of poly (hexamethylenebiguanide) on cellulose: Mechanism of binding and molecular recognition. Langmuir 2006, 22, 5636–5644. [Google Scholar] [CrossRef] [PubMed]
- Ahani, E.; Montazer, M.; Toliyat, T.; Mahmoudi Rad, M. A novel biocompatible antibacterial product: Nanoliposomes loaded with poly(hexamethylene biguanide chloride). J. Bioact. Compat. Polym. 2017, 32, 242–262. [Google Scholar] [CrossRef]
- Montemezzo, M.; Ferrari, M.D.; Kerstner, E.; Santos, V.D.; Victorazzi Lain, V.; Wollheim, C.; Olivieri da Silva Frozza, C.; Roesch-Ely, M.; Baldo, G.; Brandalise, R.N. PHMB-loaded PDMS and its antimicrobial properties for biomedical applications. J. Biomater. Appl. 2021, 36, 252–263. [Google Scholar] [CrossRef] [PubMed]
- Yuan, Y.; Chen, H. Preparation and characterization of a biodegradable starch-based antibacterial film containing nanocellulose and polyhexamethylene biguanide. Food Packag. Shelf Life 2021, 30, 100718. [Google Scholar] [CrossRef]
- Wang, Y.; Wang, C.; Xie, Y.; Yang, Y.; Zheng, Y.; Meng, H.; He, W.; Qiao, K. Highly transparent, highly flexible composite membrane with multiple antimicrobial effects used for promoting wound healing. Carbohydr. Polym. 2019, 222, 114985. [Google Scholar] [CrossRef] [PubMed]
- Mok, C.F.; Ching, Y.C.; Abu Osman, N.A.; Muhamad, F.; Mohd Junaidi, M.U.; Choo, J.H. Preparation and characterization study on maleic acid crosslinked poly(vinyl alcohol)/chitin/nanocellulose composites. J. Appl. Polym Sci. 2020, 137, 49044. [Google Scholar] [CrossRef]
- Lungu, A.; Cernencu, A.I.; Dinescu, S.; Balahura, R.; Mereuta, P.; Costache, M.; Syverud, K.; Stancu, I.C.; Iovu, H. Nanocellulose-enriched hydrocolloid-based hydrogels designed using a Ca2+ free strategy based on citric acid. Mater Des. 2021, 197, 109200. [Google Scholar] [CrossRef]
- Wang, H.; Chen, X.; Wen, Y.; Li, D.; Sun, X.; Liu, Z.; Yan, H.; Lin, Q. A Study on the correlation between the oxidation degree of oxidized sodium alginate on its degradability and gelation. Polymers 2022, 14, 1679. [Google Scholar] [CrossRef]
- Hoare, T.R.; Kohane, D.S. Hydrogels in drug delivery: Progress and challenges. Polymers 2008, 49, 1993–2007. [Google Scholar] [CrossRef]
- Qu, J.; Wang, L.; Niu, L.; Lin, J.; Huang, Q.; Jiang, X.; Li, M. Porous silk fibroin microspheres sustainably releasing bioactive basic fibroblast growth factor. Materials 2018, 11, 1280. [Google Scholar] [CrossRef]
- Maderuelo, C.; Zarzuelo, A.; Lanao, J.M. Critical factors in the release of drugs from sustained release hydrophilic matrices. J. Control. Release 2011, 154, 2–19. [Google Scholar] [CrossRef] [PubMed]
- Ye, Y.; Klimchuk, S.; Shang, M.; Niu, J. Improved antibacterial performance using hydrogel-immobilized lysozyme as a catalyst in water. RSC Adv. 2019, 9, 20169–20173. [Google Scholar] [CrossRef] [PubMed]









| Sample | DO | CC (mmol/g) | CrI (%) |
|---|---|---|---|
| u-CNFs | - | - | 28.74 a |
| c-CNFs-1 h | 0.0691 ± 0.0027 a | 0.4200 ± 0.0163 a | 32.48 b |
| c-CNFs-2 h | 0.0993 ± 0.0028 b | 0.6000 ± 0.0163 b | 40.76 c |
| c-CNFs-3 h | 0.0971 ± 0.0016 b | 0.5867 ± 0.0094 b | 41.03 c |
| Samples | Zone of Inhibition (mm) | |||
|---|---|---|---|---|
| S. aureus | P. aeruginosa | |||
| 7% c-CNFs-2 h | ND |  | ND |  |
| 7% c-CNFs-2 h/PHMB | 18.90 ± 0.37 a | | 12.47 ± 1.68 a | |
| 0.3% PHMB | 10.91 ± 0.27 b |  | 8.08 ± 0.91 b | |
Disclaimer/Publisher’s Note: The statements, opinions and data contained in all publications are solely those of the individual author(s) and contributor(s) and not of MDPI and/or the editor(s). MDPI and/or the editor(s) disclaim responsibility for any injury to people or property resulting from any ideas, methods, instructions or products referred to in the content. |
© 2023 by the authors. Licensee MDPI, Basel, Switzerland. This article is an open access article distributed under the terms and conditions of the Creative Commons Attribution (CC BY) license (https://creativecommons.org/licenses/by/4.0/).
Share and Cite
O-chongpian, P.; Chaiwarit, T.; Jantanasakulwong, K.; Rachtanapun, P.; Worajittiphon, P.; Kantrong, N.; Jantrawut, P. Surface-Modified Carboxylated Cellulose Nanofiber Hydrogels for Prolonged Release of Polyhexamethylene Biguanide Hydrochloride (PHMB) for Antimicrobial Applications. Polymers 2023, 15, 3572. https://doi.org/10.3390/polym15173572
O-chongpian P, Chaiwarit T, Jantanasakulwong K, Rachtanapun P, Worajittiphon P, Kantrong N, Jantrawut P. Surface-Modified Carboxylated Cellulose Nanofiber Hydrogels for Prolonged Release of Polyhexamethylene Biguanide Hydrochloride (PHMB) for Antimicrobial Applications. Polymers. 2023; 15(17):3572. https://doi.org/10.3390/polym15173572
Chicago/Turabian StyleO-chongpian, Pichapar, Tanpong Chaiwarit, Kittisak Jantanasakulwong, Pornchai Rachtanapun, Patnarin Worajittiphon, Nutthapong Kantrong, and Pensak Jantrawut. 2023. "Surface-Modified Carboxylated Cellulose Nanofiber Hydrogels for Prolonged Release of Polyhexamethylene Biguanide Hydrochloride (PHMB) for Antimicrobial Applications" Polymers 15, no. 17: 3572. https://doi.org/10.3390/polym15173572
APA StyleO-chongpian, P., Chaiwarit, T., Jantanasakulwong, K., Rachtanapun, P., Worajittiphon, P., Kantrong, N., & Jantrawut, P. (2023). Surface-Modified Carboxylated Cellulose Nanofiber Hydrogels for Prolonged Release of Polyhexamethylene Biguanide Hydrochloride (PHMB) for Antimicrobial Applications. Polymers, 15(17), 3572. https://doi.org/10.3390/polym15173572








